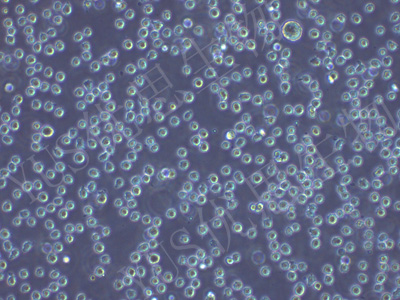

产品中心
产品中心
-

NCI-H522 人非小细胞肺癌腺癌细胞(STR鉴定)
货号:YLH145规格: 1*10^6 -

LX-2 人肝星形细胞(STR鉴定)
货号:YLH146规格: 1*10^6 -
THP-1 人单核细胞白血病细胞(STR鉴定)
货号:YLH147规格: 1*10^6 -

AAV-293 人胚肾细胞(STR鉴定)
货号:YLH148规格: 1*10^6 -

Capan-1 人胰腺癌细胞(STR鉴定)
货号:YLH149规格: 1*10^6 -

MDA-MB-436 人乳腺癌细胞(STR鉴定)
货号:YLH150规格: 1*10^6 -

CFPAC-1 人胰腺癌细胞(STR鉴定)
货号:YLH151规格: 1*10^6 -

OV-90 人卵巢癌细胞(STR鉴定)
货号:YLH153规格: 1*10^6 -

DAOY 人髓母细胞瘤细胞(STR鉴定)
货号:YLH154规格: 1*10^6 -

TE-10 人食管鳞癌细胞(STR鉴定)
货号:YLH156规格: 1*10^6 -

NCI-H1975 人肺腺癌细胞(STR鉴定)
货号:YLH157规格: 1*10^6 -

J82 人膀胱移行细胞癌(STR鉴定)
货号:YLH159规格: 1*10^6
在线咨询
Online consultation

关注微信公众号


